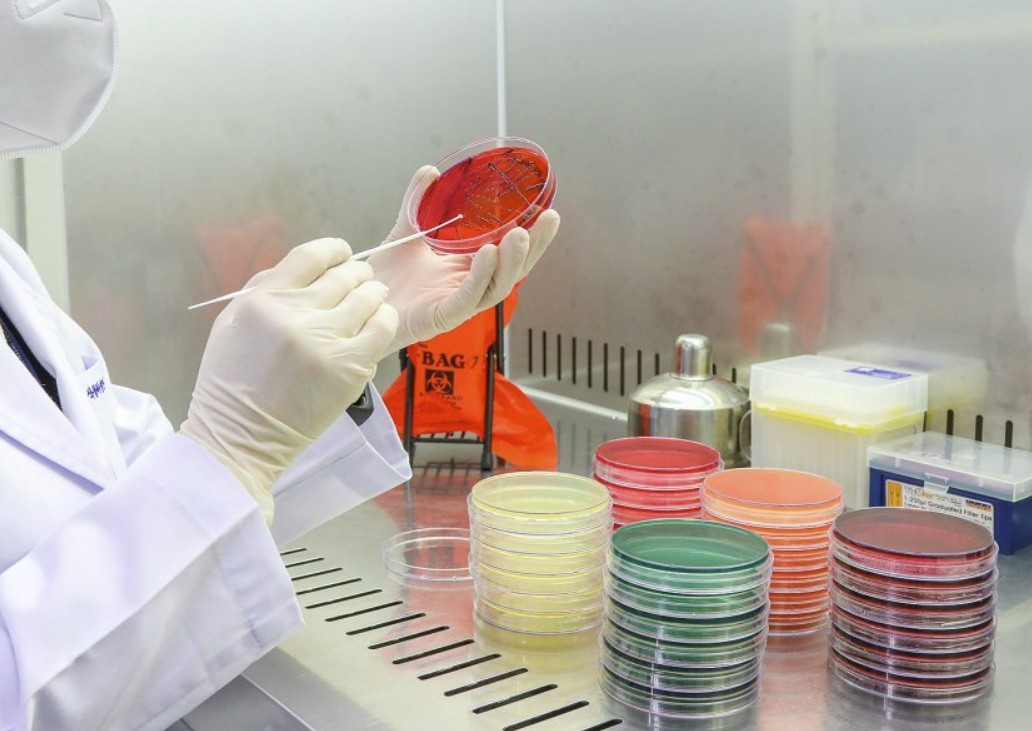
Vintage design elements

C/S service
고객만족 시스템
C/S service
고객만족 시스템
고객의견을 반영한 메뉴 결정

사람을 생각하는 식단, 건강을 담은 한 상 당신의 하루를 더 빛나게 만드는 식사